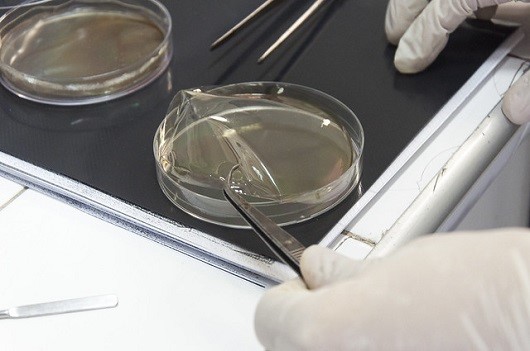

O Programa de Pós-Graduação em Biologia Estrutural e Funcional, do Centro de Biociências da Universidade Federal do Rio Grande do Norte (CB/UFRN), abre vagas para processo seletivo de mestrado. As inscrições, que seguem até o dia 5 de março, devem ser efetuadas pelo Sistema Integrado de Gestão de Atividades Acadêmicas (Sigaa).
Ao todo, são ofertadas 15 vagas, sendo 13 de ampla concorrência e duas reservadas à capacitação de servidores da UFRN, de acordo com programa de qualificação institucional. Os candidatos devem escolher entre duas linhas de pesquisa: Regulação do Organismo e Biologia celular e tecidual.
Entre os documentos necessários no ato da inscrição estão Histórico escolar de graduação, diploma de graduação, RG, CPF e currículo Lattes. Todo o processo seletivo acontece de forma remota devido à pandemia de covid-19, sendo as provas realizadas por meio da Plataforma Multiprovas da UFRN. Os candidatos devem estar com suas câmeras conectadas pelo Google Meet, utilizando link a ser enviado pela banca.
Antes do resultado final, a ser divulgado no dia 1° de abril, a seleção passa pelas seguintes etapas: homologação de inscrições, prova de compreensão de texto técnico em língua inglesa, prova de conhecimentos específicos e arguição. Eventuais recursos devem ser interpostos no dia 2 de abril, cujas respostas saem no dia 5 do mesmo mês.
Para mais detalhes sobre o processo seletivo, consulte o edital ou entre em contato com a secretaria do programa pelo e-mail pgbioef@cb.ufrn.br.